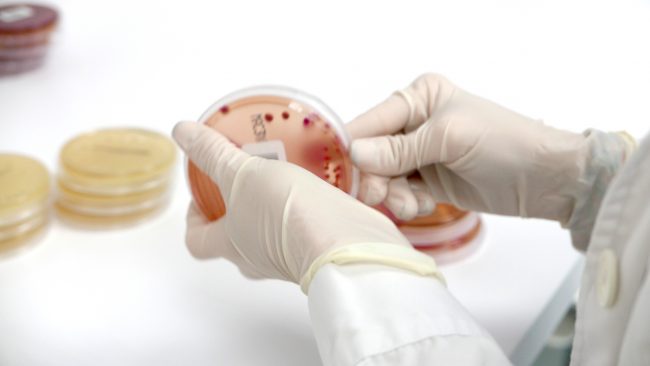
P1200338b

Control de contaminaciones microbiológicas
El control de contaminaciones microbiológicas es fundamental para asegurar la precisión de los análisis, lo que nos permite prevenir diagnósticos erróneos que podrían derivar en tratamientos inadecuados o innecesarios, afectando la salud de los animales. Además, el personal que trabaja en contacto constante con muestras que podrían contener microorganismos patógenos enfrenta riesgos para su salud,…